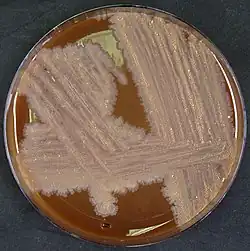

Tsukamurella hongkongensis
| Tsukamurella hongkongensis | ||
|---|---|---|
![]() Tsukamurella hongkongensis | ||
| Taxonomía | ||
| Dominio: | Bacteria | |
| Reino: | Bacillati | |
| Filo: | Actinomycetota | |
| Clase: | Actinomycetes | |
| Orden: | Mycobacteriales | |
| Familia: | Tsukamurellaceae | |
| Género: | Tsukamurella | |
| Especie: |
Tsukamurella hongkongensis Teng et al. 2016 | |
Tsukamurella hongkongensis es una bacteria grampositiva del género Tsukamurella. Fue descrita en el año 2016. Su etimología hace referencia a Hong Kong.[1] Es aerobia, inmóvil, catalasa positiva y oxidasa negativa. Crece en agar sangre con colonias anaranjadas-rojas, secas y rugosas. También crece en agar infusión cerebro corazón, TSA, agar chocolate y MacConkey. Temperatura óptima de crecimiento de 37 °C, no crece a 10 °C pero sí a 42 °C. Se ha aislado de varias muestras humanas, incluyendo un raspado corneal de un paciente con queratitis, de un hemocultivo en un paciente con bacteriemia por catéter, y de un esputo.[2]
Referencias
- ↑ Teng, Jade L. L.; Tang, Ying; Wong, Samson S. Y.; Ngan, Antonio H. Y.; Huang, Yi; Tsang, Chi-Ching; Choi, Garnet K. Y.; Lau, Susanna K. P. et al. (2016-01). «Tsukamurella hongkongensis sp. nov. and Tsukamurella sinensis sp. nov., isolated from patients with keratitis, catheter-related bacteraemia and conjunctivitis». International Journal of Systematic and Evolutionary Microbiology 66 (1): 391-397. ISSN 1466-5034. PMID 26530900. doi:10.1099/ijsem.0.000733. Consultado el 13 de agosto de 2022.
- ↑ Teng, Jade L. L.; Tang, Ying; Wong, Samson S. Y.; Fong, Jordan Y. H.; Zhao, Zhe; Wong, Chun-Pong; Chen, Jonathan H. K.; Ngan, Antonio H. Y. et al. (9 de mayo de 2018). «MALDI-TOF MS for identification of Tsukamurella species: Tsukamurella tyrosinosolvens as the predominant species associated with ocular infections». Emerging Microbes & Infections 7 (1): 80. ISSN 2222-1751. PMC 5940693. PMID 29739926. doi:10.1038/s41426-018-0083-4. Consultado el 13 de agosto de 2022.